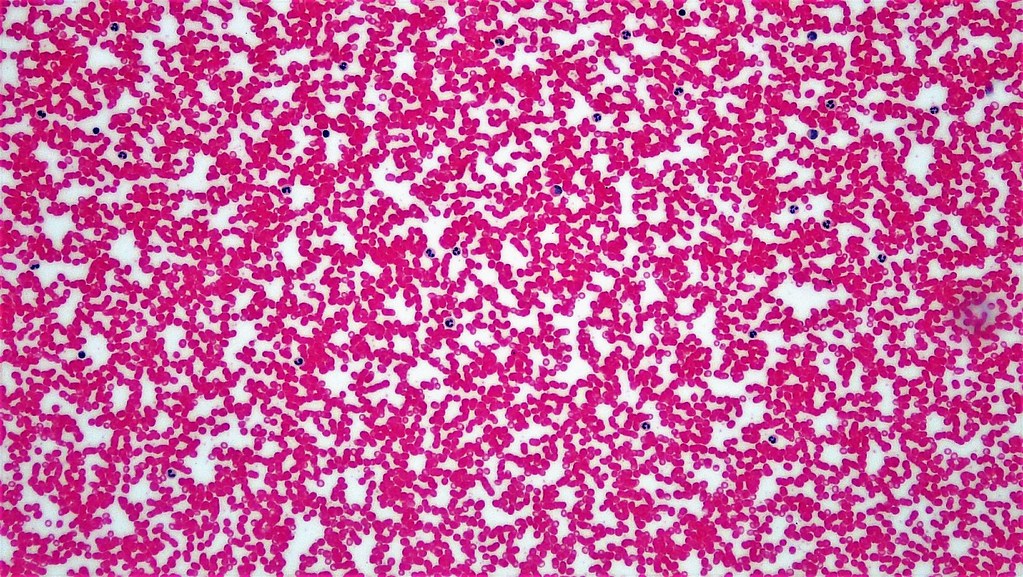

Fascia’s Relationship to Chronic Pain and Joint Degeneration
COLLAGEN’S RELATIONSHIP TO FASCIA

Collagen is the building block of all connective tissues. Some collagen-based connective tissues like bone and most cartilages, are part of your body’s load-bearing framework. Their purpose is to withstand “compressive” forces, while grossly maintaining the body’s shape. On the other hand, you have the elastic, collagen-based, connective tissues, whose chief job is to overcome the “tensile” forces that are constantly trying to pull joints apart. These particular tissues don’t need to be able to bear heavy loads, but instead, must be able to stretch and elast (to at least a slight degree) while resisting tearing. These “elastic” collagen-based connective tissues include ligaments, tendons, muscles, and fascia. It is fascia we are concerned with here.
Although you may have never heard the term “fascia” before, you undoubtedly have seen it and know what it is. It is the thin (almost translucent), white / yellow membrane that tightly surrounds muscles – or a pot roast. Deer hunters in our area call it “Striffin”. The term “fascia” comes from the Latin word meaning “band” or “bandage,” which is appropriate, because it is like a very thin ligamentous sheath or band.
A GENERIC DEFINITION OF FASCIA:
“Fascia are the tough layers of fibrous, collagen-based connective tissues that permeate the human body throughout. Fascia is the thin, cellophane-like, connective tissue that surrounds muscles, groups of muscles, blood vessels, and nerves; binding these structures together in much the same manner that plastic wrap can be used to hold the contents of a sandwich together. Fascia is the tissue where the musculoskeletal system, circulatory system, and nervous system, all converge. Fascia consists of several layers, and extends uninterrupted from the top of the head to the tip of the toes. Like ligaments and tendons, fascia contains closely packed bundles of wavy collagen fibers that are oriented in a parallel fashion. Subsequently, healthy fascia are flexible structures that are able to resist great uni-directional tension forces.”
WHAT DOES FASCIA DO?
Be aware that most anatomical drawings do not show much fascia. This leads to the erroneous view that fascia is not an important tissue, even though it makes up approximately 1/3 of the tissue that is found in a muscle. There are several critical functions of the fascia:
- It binds and holds muscles together in a compact package.
- It ensures proper alignment of the muscle fibers, blood vessels, nerves, and other tissue components inside the muscle.
- It transmits forces and loads, evenly throughout the entire muscle.
- It creates a uniformly smooth surface that essentially “lubricates” the various surfaces that come in contact with each other during movement.
- It allows the muscle to change shape as they lengthen or shorten.
As long as the individual collagen fibers that make up the fascia, are aligned in parallel fashion to each other, the tissue is stretchy and elastic (think about long hair that has been combed out. If you run a comb or brush through it, it glides — smoothly and unrestricted). But what happens when fascia is injured?

INJURED FASCIA
When fascia is stretched beyond its normal load-bearing capacity, it begins to tear. Bear in mind that these tears are so microscopic that they never show up on an x-ray, and only on rare occasions (possibly the Plantar Fascia) will they show up on an MRI. Fascial tears can be caused by sports injuries, repetitive trauma, car wrecks, postural distortions, falls, child bearing, abuse, etc, etc, etc. Very often people have no idea how they ended up with fascial adhesions.
Whenever a muscle is impacted (contact sports, falls, abuse, etc), or overused (lifting weights, running, over-training, heavy or repetitive jobs, etc); collagen microfibers form in between adjacent layers of fascia to bind them together so that the muscles can heal. These microfibers act like a cast. Unfortunately, they do not go away after the area has healed, and tend to accumulate over time. This means that over time, the elastic, collagen-based tissues (particularly muscles and fascia) get increasingly stiffer and less stretchy.
Once fascia is injured (stretched, pulled, torn, etc.), the microscopic fibers become disrupted and deranged. Instead of fibers running parallel to each other in an organized fashion with their normal degree of elasticity / flexibility, the fibers now run every possible direction — in all three dimensions. This is called a scar, and as you can see, scar tissue (no matter how microscopic it is) has an extremely diminished amount of organization and elasticity. Interlock the fingers from one hand with the fingers from the other, only do it with the fingers pointed in all directions. Now try to slide the hands back and forth. See the difference in flexibility? The fact that the fingers are running in a non-parallel fashion to each other greatly diminishes flexibility.
Also notice that when the fingers are interlocked randomly, they will no longer lay flat on the table. Facial adhesions act the same way. When fascia is injured, individual fibers run every which direction, in all three dimensions. This means that the fascial membranes no longer lay flat like a piece of paper. Instead, they are more like a wadded up or crumpled piece of paper. Unfortunately, injured fascia frequently heals in this tangled, twisted, and wadded-up manner.
We can also think of this fascial scarring and adhesion in terms of hair. Remember our example of well-manicured hair that a comb or brush glides through easily? Now think of the exact opposite. Think of a hair tangle. What happens to hair that is not well taken care of, or was slept on wet? Instead of the individual hair follicles lying parallel to each other in a neat and orderly fashion, they become tangled with the individual hair fibers running in every conceivable direction. The result is a tangled mess — a ball of hair that takes forever just get a comb or brush through it. “Hair balls” can be so restrictive that just trying to get a comb through it, pulls and causes great pain. This is even more true with fascia. Most people are unaware that fascia is believed to be the single most pain-sensitive tissue in the human body!
INJURED FASCIA LEADS TO LOSS OF MOTION, & LOSS OF MOTION IS THE KNOWN CAUSE OF JOINT DEGENERATION
When the organization of the parallel collagen fibers of fascia are disrupted by injury, a host of really bad things begin to happen. The first thing that occurs is restriction of joint motion. Understand that if you have tissue restriction, you will automatically have some degree of loss of normal joint motion in the corresponding area(s) of the body. Also understand that loss of normal joint motion virtually assures you that sooner or later there will be pain – even if you are not yet experiencing pain. Unfortunately, pain is not the worst thing that is caused by loss of normal joint motion. That would be degeneration.
Loss of, or abnormal joint motion, is the known cause of localized joint degeneration. When I speak of “localized joint degeneration“, I am talking about things like calcium deposits, bone spurring, and loss of articular cartilage or disc height. Degeneration is a great example of a “vicious cycle“: Loss of joint motion causes joint degeneration — and joint degeneration causes loss of normal joint motion. Repeat. As this cycle spins around and around, it causes pain.
STOP! Think for just a moment. Pain is nothing more than a by-product of the vicious cycle. This is why pain pills and other similar measures (drugs), mask symptoms of Chronic Pain (ineffectively, I might add) without ever addressing its underlying cause. In many cases of Chronic Pain, the underlying cause is fascial restriction and microscopic scar tissue.
Think for a moment how problematic this whole scenario is. Fascia is the single most pain-sensitive tissue in the body — yet it does not image well with even the most advanced imaging technologies such as MRI! What does this mean? Those of you who have dealt with Chronic Pain long enough, know exactly what it means!
It means that when you go visit various doctors (orthopedists, pain specialists, neurologists, etc) they run all sorts of tests, and then look at you as though you are crazy. Or maybe they look at you like you’re a drug seeker, or trying to get Social Security Disability, or trying to win a work comp settlement. Or maybe they just chalk it up to hard work and too many sports. Or maybe they just tell you that you have “arthritis” or “fibromyalgia” in order to get you out of their office. Or maybe they just use that old and trusted standby, “After all Mrs. Smith, you just aren’t as young as you used to be.“
Whatever the case, the result is almost always the same. A blank stare and the recommendation for more pills — or maybe even corticosteroid injections. The latest medical “treatment” for Chronic Pain involves putting people on SSRI’s (anti-depression drugs) while trying to convince them that their Chronic Pain is the result of depression; when just the opposite has been proven to be closer to the truth. (Clinical Depression has not been shown to cause Chronic Pain, but Chronic Pain can cause Depression).
YOU WERE PRESCRIBED “WHAT” FOR YOUR INJURY?
Oh, and how about your doctor kick you a few more times while you are down. Scientific studies have repeatedly shown that beyond the wide array of dangerous, and even deadly side-effects to the kidney, liver, and heart; both NSAIDS, and cortico-steroids actually deteriorate collagen-based tissues — severely and rapidly. This is why doctors will usually ration the amount of cortisone you can have, even if it helps your pain. The Journal of Bone and Joint Surgery published a study over a decade ago that said if a person has more than one cortico-steroid injection in the same joint, over the course of their lifetime, their chance of developing premature deterioration of the affected joint is 100%. Gulp!

IF THE DRUGS ARE SO BAD FOR MY CONNECTIVE TISSUES, WHAT DO I DO?
Instead of treating the Elastic Collagen-Based Tissues (Muscles, Tendons, Ligaments, and Fascia) using the outdated model based on the old belief that “inflammation” (“itis“) is the primary cause of the majority of the problems in these tissues; I believe patients deserve something better – something that actually works.
Because the very drugs that doctors use to reduce inflammation are actually known to cause deterioration of collagen, you should begin to see that something is rotten in Denmark.
I use something called I.I.R.E.C-B.C.T. (Instrument Induced Remodeling of the Elastic, Collagen-Based Connective Tissues). This form of Tissue Remodeling is not the latest electronic “gizmo”. Nor is it some “Johnny-come-lately“. It has been around in various forms (particularly in Chinese Medicine) for thousands of years. However, it has only been around in its current form for twenty years or so. It allows the doctor to find and effectively address Fascial Adhesions or “osis” (osis means that tissue is deranged and not merely inflamed).
I use a bodywork technique called Brain.Body.Balance. to assist release the fascia, re align and neurally rewire movement patters, interested?
To book a session o get more information email: info@lucianapierangeli.com
A significant portion of the Chronic Pain that so many people suffer with, is intimately related to Microscopic Adhesions or “Scar Tissue” of the Elastic, Collagen-Based Connective Tissues (ligaments, tendons, muscles, and fascia). A few of the problems that can arise as the result of Microscopic Scarring of these tissues include things like Chronic Neck or Back Pain, Headaches, Piriformis Syndrome, Tendinitis / Tendinosis, chronic muscle pulls, many Sports Injuries, shoulder and Rotator Cuff problems, Bursitis, Degenerative Arthritis, Carpal Tunnel Syndrome, and numerous others.
By Dr Russell Schierling
Article Source: ezinearticles.com/6298636






